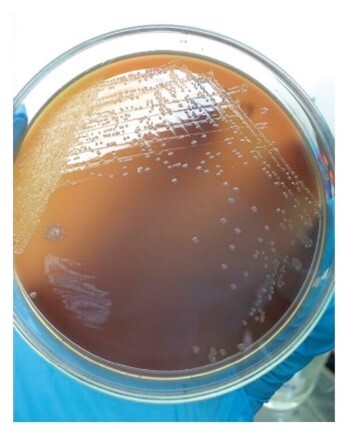
Decorative
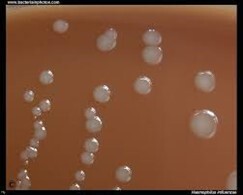
Decorative

48 hours incubation


24 hours incubation:
appearance similar to Haemophilus influenzae

very small, gram-negative coccobacillus/coccus; individual organisms are difficult to see.

small gram-negative coccobacillus with well-defined individual organisms
